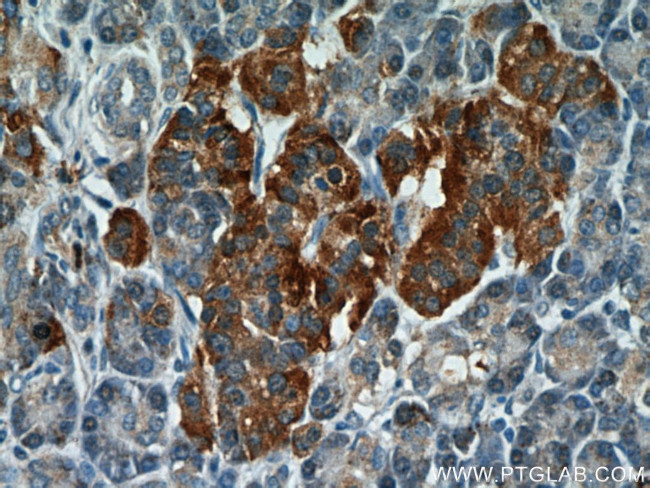
C7orf10 Antibody in Immunohistochemistry (Paraffin) (IHC (P))
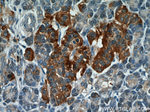
C7orf10 Antibody in Immunohistochemistry (Paraffin) (IHC (P))

Search
Proteintech
C7orf10 Polyclonal Antibody
{{$productOrderCtrl.translations['antibody.pdp.commerceCard.promotion.promotions']}}
{{$productOrderCtrl.translations['antibody.pdp.commerceCard.promotion.viewpromo']}}
{{$productOrderCtrl.translations['antibody.pdp.commerceCard.promotion.promocode']}}: {{promo.promoCode}} {{promo.promoTitle}} {{promo.promoDescription}}. {{$productOrderCtrl.translations['antibody.pdp.commerceCard.promotion.learnmore']}}
产品信息
21589-1-AP
种属反应
宿主/亚型
分类
类型
抗原
偶联物
形式
浓度
规格
纯化类型
保存液
内含物
保存条件
运输条件
产品详细信息
Immunogen sequence: VKIIKELAA VCDVFVENYV PGKLSAMGLG YEDIDEIAPH IIYCSITGYG QTGPISQRAG YDAVASAVSG LMHITGPENG DPVRPGVAMT DLATGLYAYG AIMAGLIQKY KTGKGLFIDC NLLSSQVACL SHIAANYLIG QKEAKRWGTA HGSIVPYQAF KTKDGYIVVG AGNNQQFATV CKILDLPELI DNSKYKTNHL RVHNRKELIK ILSERFEEEL TSKWLYLFEG SGVPYGPINN MKNVFAEPQN AVSGFQSLLH SLAHGPFLHL QGSARVLHNG LVMEMEHPTV GKISVPGPAV RYSKFKMSEA RPPPLLGQHT THILKEVLRY DDRAIGELLS AGVVDQHETH (123-471 aa encoded by BC098318)
靶标信息
SUGCT (Succinyl-CoA:Glutarate-CoA Transferase) is a Protein Coding gene. Diseases associated with SUGCT include Glutaric Aciduria Iii and Noonan Syndrome 8. Gene Ontology (GO) annotations related to this gene include succinate-hydroxymethylglutarate CoA-transferase activity. An important paralog of this gene is AMACR.
仅用于科研。不用于诊断过程。未经明确授权不得转售。
生物信息学
蛋白别名: C22orf6; Dermal papilla-derived protein 13; Dicarboxyl-CoA:dicarboxylic acid coenzyme A transferase SUGCT; KIAA1186; KIAA1658; Russel-Silver syndrome candidate; Succinate--hydroxymethylglutarate CoA-transferase; Succinyl-CoA:glutarate CoA-transferase; succinylCoA:glutarate-CoA transferase; unnamed protein product
基因别名: 5033411D12Rik; C7orf10; D17907; DERP13; GA3; ORF19; RGD1308114; SUGCT
UniProt ID: (Human) Q9HAC7, (Rat) Q68FU4, (Mouse) Q7TNE1
Entrez Gene ID: (Human) 79783, (Rat) 361253, (Mouse) 192136